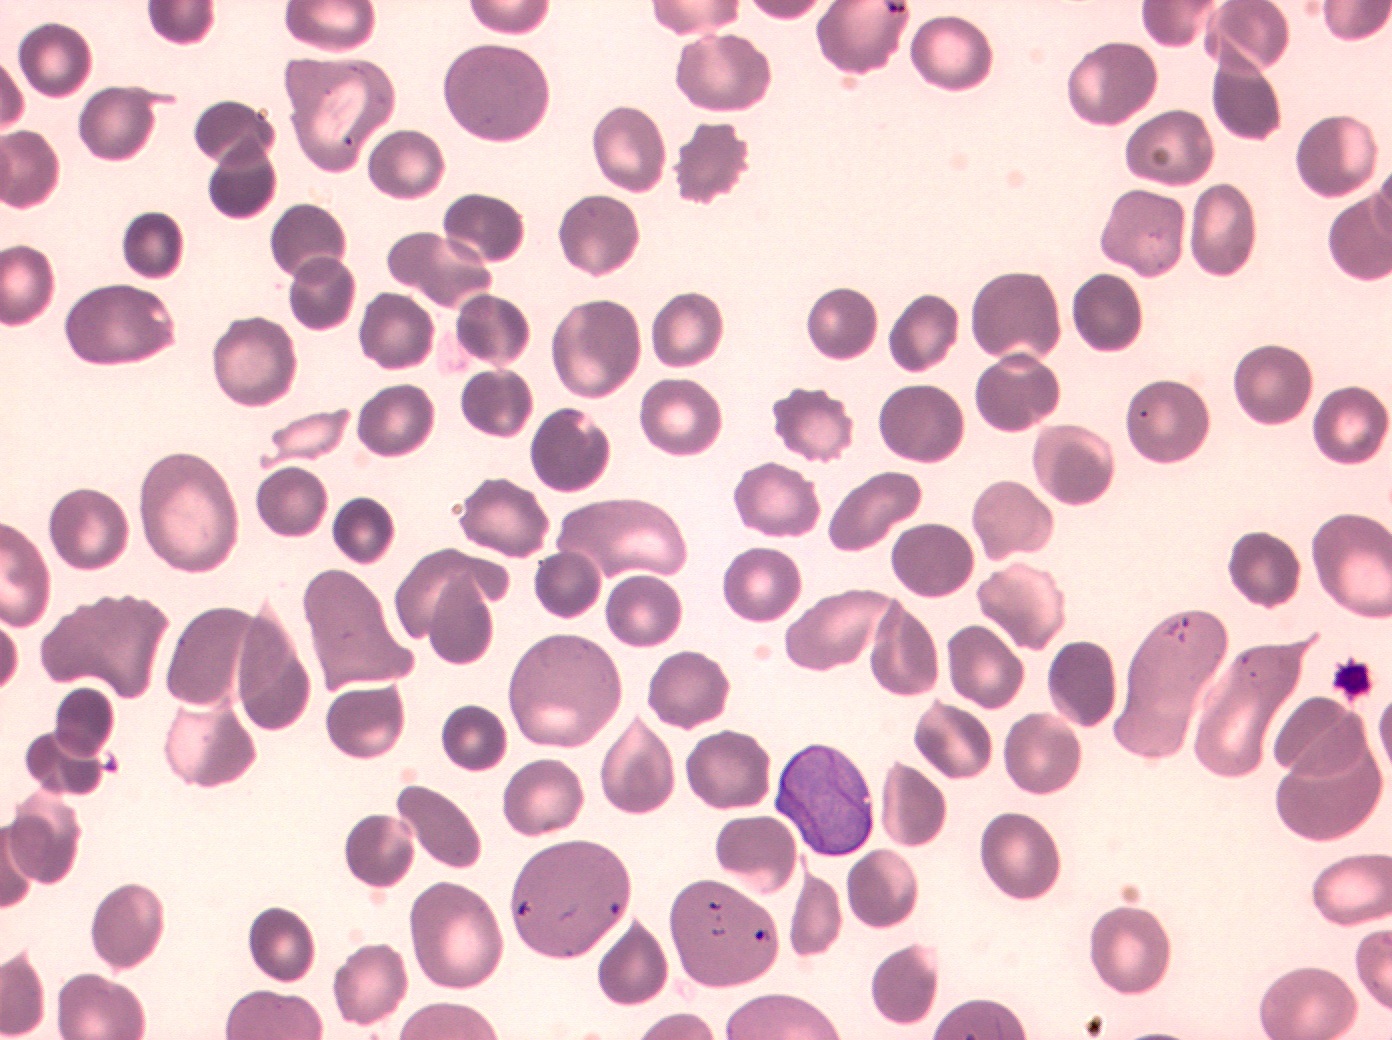

Эритроциты при лейкозе
Эритроциты при лейкозе 100 фотографий
Astra h bluetooth
Vector погрузчик
Соколово коми
Цикламен мини
Лютики цветочки женитьбы бальзаминова
Клубника которая плодоносит все лето
Простой экономического характера
Сью джонсон обними читать
Камеди клаб приветствие лучшее
3 пенетрация